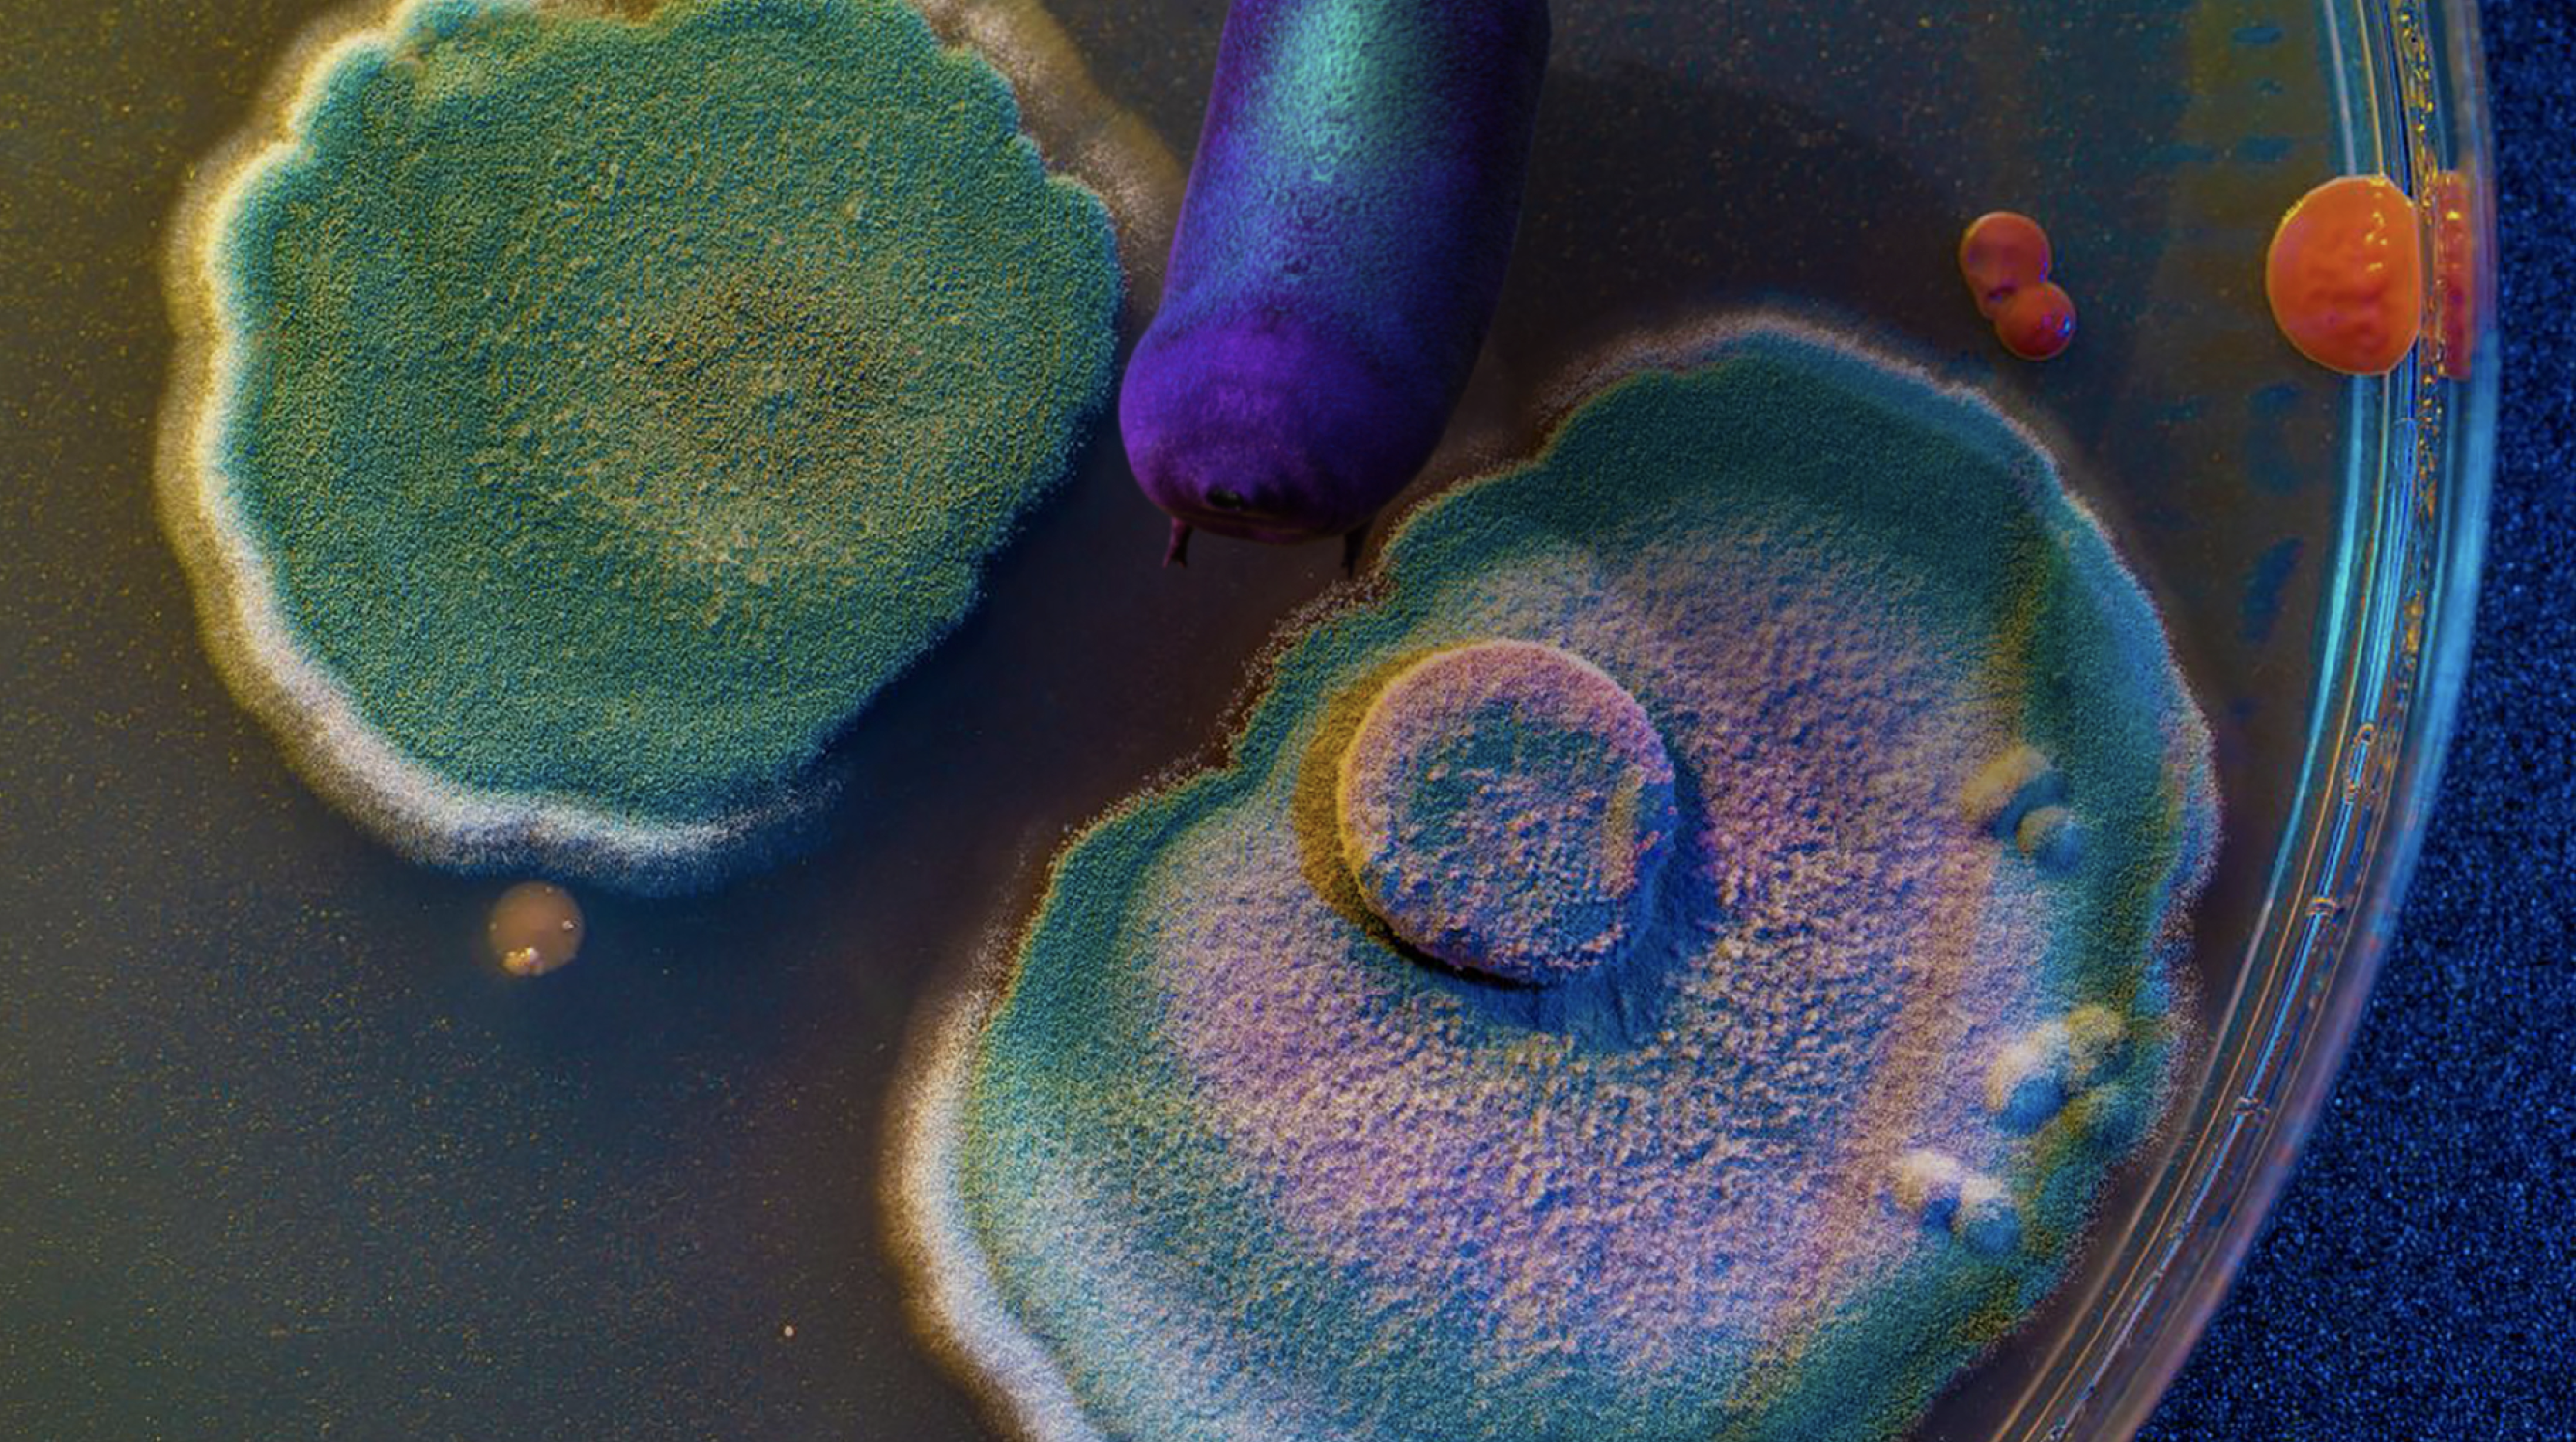

“The internet has gone from being a tool we use to a place we live”
I don’t remember who said that first, but I think about that quote a lot.
Hi, my name is Rebecca, and this is where I live. Make yourself at home.
Hi, my name is Rebecca, and this is where I live. Make yourself at home.
CV
︎ r.mesonjnik@gmail.com
︎ @becca.meh
Design
A Brief History of American Myths
Learning to Listen
DamnGetHip
Illustration
Prints
3D Modeling
Editorial
Motion Graphics
How to Help a Fellow New Yorker
The Anthologies of Karpo
Design
A Brief History of American Myths
What makes America? This is a question I ask myself constantly. As a child of immigrants I am always being pulled in two directions, either I must honor my parent culture or assimilate into American society.
In the first half of my thesis, I explore what “being American” means on a personal level. I investigate how immigrants fit into our national identity, and why we categorize them as “other” while fetishizing their narrative.
Drawing on personal experience and interviews with other children of immigrants, I attempt to debunk the Bootstrap myth (the success of immigrant generations decreases the longer they live in America). In the process I pose questions about who shapes our collective identity and what it means to aspire to the American dream.
This personal experience with American myth-making inspired the second half of my thesis project.
A Brief History of American Myths investigates the source of American identity, inspired by my own experience of blindly accepting everything I read in history books, only to later find out that there was much more to history, and what we were taught as children purposefully omitted the stories of marginalized groups.
After speaking with others whose experiences mirrored my own, I wanted to know what untruths we may have internalized and regurgitated as fact. Through this book I hope to encourage others to begin the process of uncovering the truth.
In the first half of my thesis, I explore what “being American” means on a personal level. I investigate how immigrants fit into our national identity, and why we categorize them as “other” while fetishizing their narrative.
Drawing on personal experience and interviews with other children of immigrants, I attempt to debunk the Bootstrap myth (the success of immigrant generations decreases the longer they live in America). In the process I pose questions about who shapes our collective identity and what it means to aspire to the American dream.
This personal experience with American myth-making inspired the second half of my thesis project.
A Brief History of American Myths investigates the source of American identity, inspired by my own experience of blindly accepting everything I read in history books, only to later find out that there was much more to history, and what we were taught as children purposefully omitted the stories of marginalized groups.
After speaking with others whose experiences mirrored my own, I wanted to know what untruths we may have internalized and regurgitated as fact. Through this book I hope to encourage others to begin the process of uncovering the truth.






Who Makes America?





As I continued to develop my thesis proposal, I decided to write an editorial piece on immigration success rates and the experiences of second generation immigrants (children who arrived in the host country at a young age or whose parents are immigrants) like myself. It combined my interests of design, data visualization, and editorial illustration into one cohesive piece, and referenced the poster I designed earlier in my thesis.
Who Makes America? was the product of my thesis research into the immigrant experience in New York. My research resulted in one poster which I posted around Flushing, Queens. I chose this neighborhood because I spent a significant portion of my childhood there, and it is known for its large immigrant population.
Unfortunately due to the pandemic and xenophobia, Flushing has been hit hard socially and economically. My intent for this poster was to spread a message of inclusivity and highlight the achievements of the immigrant population that resides there.
I chose to mimic the infamous “Instructions to all Persons of Japanese Ancestry” document as a way to upend the original message. Where once this poster was a symbol for division perpetrated by the U.S. government, now it would spread truth and inclusivity.
Unfortunately due to the pandemic and xenophobia, Flushing has been hit hard socially and economically. My intent for this poster was to spread a message of inclusivity and highlight the achievements of the immigrant population that resides there.
I chose to mimic the infamous “Instructions to all Persons of Japanese Ancestry” document as a way to upend the original message. Where once this poster was a symbol for division perpetrated by the U.S. government, now it would spread truth and inclusivity.




Learning to Listen
Learning to Listen was my response to a course taught by Julia Furlan called Podcasting and Audio Narritives. The final assignment for the class was to create a zine documenting what we learned during the class and any reflections we had.
I chose to document my own listening journey, from a small bilingual child to the present day, with illustrations accompanying the text to move the story forward.
I chose to document my own listening journey, from a small bilingual child to the present day, with illustrations accompanying the text to move the story forward.
Damn Get Hip



Damn Get Hip is an anagram of mind the gap, as in “mind the gap between the train and the platform.” Damn get hip is a hand-coded site with illustrations and text by me.
This site was a receptacle for the memories I have of NYC, beginning from my first time on the train with my mom to a drunken night out in Union Square.
Illustration
Prints
Lithography and block printing





3D Modeling

A little tardigrade character named Jesk who I modeled in Maya at various stages and environments. A tardigrade, sometimes known as a water bear or a moss piglet, is a microscopic creature that can survive in extreme environments. I thoroughly enjoyed this project simply because my subject was so cute.
Editorial Illustration
Motion Graphics
How to Help a Fellow New Yorker




A series of gifs from a motion graphics piece I completed which discussed the unfair price hike of metro cards and the unnecessary increased police presence inside the subway.
This video provides viewers with instructions on how they can help those who cannot afford a fair and protest over-policing in their communities.
The Anthologies of Karpo




A multi-part series where we follow a space cowboy’s journey through the universe.
CV
Education
Parsons School of Design - New York, NY August 2017 to Present
Bachelor of Fine Arts in Communication Design, Minor in Journalism and Design
Expected graduation date May 2021 | GPA 3.84
Visual Editor, New School Free Press
Dean’s Scholarship Recipient | Lang CESJ Grant Recipient
Work Experience
Community Resource Assistant August 2020-Present
Senior Resident Advisor August 2019 to March 2020
Resident Advisor May 2018 to August 2019
The New School | New York, NY
Create events and host regular community meetings for over fifty students. Act as a peer mentor to students and staff in the residence hall and the university. Coordinate a shift schedule and act a peer mentor for twelve Resident Advisors. Functioned as the advisor to Hall Council which organized events attended by over one hundred students.
Intern November 2018 to May 2019
Urban Justice Center | New York, NY
Assisted attorneys who advocate for secure housing for underserved communities in New York City by contacting clients, completing administrative tasks, and composing legal documents.
Artist Assistant November 2019 to December 2019
Johannah Herr | New York, NY
Assisted the artist in a mural installation at the BRIC House in Downtown Brooklyn.
Intern July 2016 to August 2016
Andrea Arroyo | New York, NY
Worked with the artist to manage social media accounts and construct and install artwork at the Morris –Jumel Mansion Museum in NYC.
Skills & Interests
Excellent understanding of Composition/Typography/Color Sense/ Composition/Research (Design Thinking)
Adobe Creative Suite: Adobe Indesign/Adobe Illustrator/Adobe Photoshop/Adobe AfterEffects/Adobe XD
Proficient in Autodesk Maya
Proficient in data entry
Proficient in lithography and relief printmaking/bookmaking and bookbinding
Proficient in Microsoft Office and Google Suite
Proficient in HTML/CSS
Native Russian speaker
Prototyping/Wireframing /Storyboarding
Branding/ Editorial layout
Motion Graphics
Illustration
Art Directing/Styling